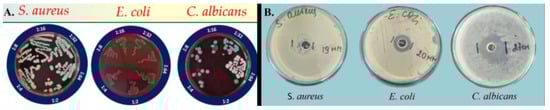

Abstract
The current research is focused on the discovery and optimization of an effective cosmetic carrier of alpha-bisabolol as a first step in the development of a cosmetic product with cleansing and antimicrobial action for facial skin hygiene. A micellar solution of Poloxamer 407 was selected as a cosmetic base because of the good washing ability, easy application, and high tolerability of this polymeric surfactant. The solubilization capacity of a 5% micellar solution with respect to α-bisabolol was investigated by applying varying solubilization techniques and increasing concentrations of the oily active substance. The test samples were subjected to an accelerated physical stability test, viscosimetry, dynamic light scattering (DLS), electrophoretic light scattering (ELS), foamability test, and antimicrobial screening. Over the course of this research, the advantage of the film-hydration method over direct solubilization was demonstrated by the narrower size distribution and smaller hydrodynamic size of the micellar nano-carriers (ranging from 29.02 to 116.5 nm) and the respective higher physical stability of the dispersions. The optimized composition was found to be suitable for application on large skin areas in terms of viscosity in the temperature range from 20 °C to 40 °C (3.4–2.3 mPa.s). Preservation of the washing capacity of the micellar solution in the presence of solubilized α-bisabolol was established. The active composition demonstrated inhibitory activity against Staphylococcus aureus and Escherichia coli and fungicidal activity against Candida albicans. This study concludes that the optimal concentration of α-bisabolol to be solubilized in a 5% Poloxamer 407 micellar solution by the film-hydration technique is 1%, considering the desirable physical endurance and antimicrobial activity.
1. Introduction
Bisabolol is a naturally occurring bioactive compound (BAC) with a structure of monocyclic sesquiterpene alcohol. First derived from Matricaria chamomilla, it is today identified as a main constituent of several essential oils of aromatic plants belonging to the Asteraceae and Lamiaceae families (e.g., Vanillosmopsis sp., Salvia runcinata, Stachys lavandulifolia) [,]. The most active and prevalent α (-) diastereoisomer of bisabolol is also known as levomenol. It is a colorless, oily liquid with a low density (0.93 g/cm3) and a sweet scent. As a strictly lipophilic compound, α-bisabolol possesses negligible solubility in water (1.688 mg/L at 25 °C) but is soluble in ethanol and other polar organic solvents [,,]. In cosmetics and topical pharmaceuticals, α-bisabolol finds a broad application as an anti-inflammatory, antioxidant, and anti-allergic active component; furthermore, it exhibits antimicrobial, insecticidal, melanogenesis-inhibiting, and permeation-enhancing properties []. On the current market, α-bisabolol is found primarily in macroemulsion-type formulations—lotions and creams or lipophilic ointments (balms)—designated as anti-inflammatory, soothing, smoothing, whitening/brightening, restorative, moisturizing, anti-aging, sunscreen, or after-sun products [,,].
Micellar solubilization is a technique for increasing the water solubility of slightly soluble or practically insoluble substances by including them in micelles of surfactants []. As a result, a thermodynamically stable and isotropic system is formed []. The method is highly relevant for the preparation of aqueous dispersions of lipophilic ingredients, such as bisabolol and many other BACs, for cosmetic and pharmaceutical purposes [,,,]. Polymeric micellar nano-carriers are successfully utilized in the dermal drug delivery of oleanolic acid and co-enzyme Q10 for anti-aging therapy [,]; tretinoin (all-trans retinoic acid), adapalene, and benzoyl peroxide within anti-acne formulations [,,,]; tacrolimus and resveratrol in formulations designated for the treatment of psoriasis [,]; and clotrimazole, fluconazole, and terconazole for local anti-fungal therapy, amongst others [,,].
The ability to solubilize is inherent to surfactants with a high hydrophilic–lipophilic balance (HLB) value (>10). Upon reaching their critical micelle concentration (CMC) in aqueous solutions, they tend to self-aggregate spontaneously and form distinct structures comprising a hydrophobic core and a hydrophilic crown called micelles. The micellar inclusion of strictly hydrophobic substances occurs in the micellar core, whereas partially water-soluble substances with low to moderate hydrophobicity may also become solubilized in the micellar crown among the hydrophilic chains [,]. The resulting dispersion is referred to as a microemulsion and is characterized by the presence of nano-sized micelles (most often within the range of 5–20 nm). In contrast to classic emulsions (typically with a droplet size of 1–100 µm), microemulsions possess thermodynamic stability and transparency [,,]. The most commonly used solubilizers in cosmetic products are sodium oleate (HLB 12), Polysorbate 20 (HLB 17), Polysorbate 80 (HLB 15), some PEG-ylated vegetable oils (olive, castor, etc.) and Poloxamers (e.g., subspecies 124, 188, 407, etc., with HLB in the range 18–23). Generally, effective solubilization is a complex procedure and requires a high amount of surfactant/s above 3–5 times the amount of the water-insoluble phase [,]; the successful formulation of a microemulsion and the realization of the characteristics mentioned above are a matter of precise modeling of the type and combinations of surface-active agents. Today, it is known that the HLB approach is limited and does not offer satisfactory predictability and practical applicability with respect to optimal surface tension reduction and phase behavior. Although the HLB value of surfactants is still a standard and a pharmacopoeial parameter, in the process of formulating microemulsions, most researchers turn to comprehensive algorithms that take into account the surfactant’s nature and other essential formulation variables (e.g., salinity, temperature, co-surfactants, hydrophobicity of the oil phase) [,,].
Poloxamers are nonionic copolymers with a triblock architecture of a repeating structural unit comprising two hydrophilic ethylene oxide (EO) blocks and a transitional hydrophobic propylene oxide (PO) block between them. The various subtypes of Poloxamers differ in molecular weight, poly (propylene oxide) (PPO) content, and consistency. Due to their unique properties as emulsifiers, solubilizers, wetting agents, and thermo-sensitive gelling agents, the Poloxamers are widely used in the cosmetic and pharmaceutical industries, with subtypes 188 and 407 being the most universally utilized [,].
According to the European Pharmacopoeia, Poloxamer 407 is characterized by a molecular mass of 9840–14,600 g/mol, HLB 22, and a content of 95–105 EO and 54–60 PO units. It appears as white or almost white, waxy granules or flakes and is soluble in water and ethanol and practically insoluble in oils []. Poloxamer 407 exhibits temperature-dependent dissolution and gelation due to the dehydration of the PPO blocks at elevated temperatures. The CMC of Poloxamer 407 decreases with the increase in temperature; values of 0.7% w/w at 25 °C, 0.1% w/w at 30 °C, and 0.025% w/w at 35 °C have been reported []. Gelation occurs upon reaching the critical gelation concentration (CGC) due to a tight “packing” of the Poloxamer micelles, wherefore more concentrated solutions (>13–15% w/w) find a broad application in biomedicine. As gelation is determined by temperature, critical gelation temperature (CGT) is also defined; variations in CGT at a given Poloxamer concentration are observed in the presence of active ingredients or excipients []. In a gel state, Poloxamer 407 is used as a viscosity-enhancing and thickening ingredient; however, in the role of emulsifier and solubilizer in liquid bases, Poloxamer 407 is used in concentrations lower than its CGT/CGC in order to preserve the fluidity and easy application of the composition on extensive skin areas. In this regard, micellar solutions with concentrations in the range of 1–5% are reported to possess a good washing effect and are thus eligible as cosmetic bases with a cleansing effect [,,]; in the presence of a water-insoluble phase for solubilization in the Poloxamer solution, the upper limit of this range is to be targeted.
Several techniques are applied for solubilization with the use of Poloxamers, among which are direct solubilization, solubilization via the film-hydration method, solubilization by melting, and solubilization by a precipitation technique followed by evaporation/diffusion of an organic solvent []. Direct solubilization (DS) is the most straightforward approach based on the spontaneous micelle formation in aqueous Poloxamer solutions above the CMC. Depending on the active compound’s solubility, DS could be carried out by dilution of a Poloxamer concentrate containing the substance to be solubilized or by a simultaneous dissolution of the polymer and the active ingredient in cold water (5–10 °C) and subsequent tempering at room temperature, during which the solubility of the Poloxamer decreases and a micro-heterogeneous system is formed []. The film-hydration method (FH) is based on the co-dissolution of the polymer and the active substance in an organic solvent (e.g., ethanol, acetone, chloroform) followed by evaporation so that a thin film is formed. The next steps of this technique include hydration of the film and following filtration, aiming for micellar size calibration []. Solubilization by melting could be carried out by obtaining a melt of the polymer and the active substance (at a temperature above the melting point of the substance and above the glass transition of Poloxamer), followed by rapid cooling and homogenization of the mixture. This method is only suitable for the solubilization of thermally stable substances. Additionally, varieties of precipitation techniques with subsequent solvent evaporation and/or diffusion are applied in order to obtain nano-sized actively loaded micelles in an aqueous dispersion [].
The objectives of this study were to carry out a pilot investigation on the solubilization of bisabolol in simple Poloxamer 407 micelles; to compare the solubilization capacity of Poloxamer 407 for bisabolol by applying different technological approaches; to establish a stable formulation eligible for application as micellar solution for maintaining facial skin hygiene; and to investigate the antimicrobial activity of the optimized formulation and therefore define the need for and course of further technological development.
2. Materials and Methods
2.1. Materials
Alpha-bisabolol 85% 10 mL, extracted from Matricaria chamomilla, was ordered from an online trader at www.ekomama.net; Kolliphor® P407 (Poloxamer 407) and Ethyl alcohol 96% 2.5 L were purchased from Sigma-Aldrich, St. Louis, MI, USA; all microbial strains and growth media were supplied by Ridacom, Sofia, Bulgaria.
2.2. Methods
2.2.1. Preparation of Test Samples
Bisabolol-loaded micellar solutions were prepared at a constant Poloxamer concentration of 5% and varying concentrations of the active substance—0.5%, 1.0%, and 1.5%. The techniques of direct solubilization and solubilization by the film-hydration method were applied (Figure 1).

Figure 1.
Principles of direct solubilization (DS) and solubilization via film hydration (FH).
For the purposes of direct solubilization, a 20% Poloxamer concentrate was prepared by dissolving the polymer in cold water and storing the so-obtained stock solution in a refrigerator for at least 24 h before use. Then, a calculated amount of α-bisabolol was added to the Poloxamer concentrate under continuous stirring at 1000 rpm using an IKA® magnet stirrer model (C-MAG HS 4, Staufen, Germany). The resulting primary solubilizate was diluted with distilled water in a 1:4 ratio, and the mixture was allowed to homogenize at the same rotation speed for 10 min. A reference 5% Poloxamer 407 solution (not loaded with bisabolol) was prepared accordingly and used for comparative purposes during the analyses.
Sample preparation via the film-hydration method was carried out by simultaneously dissolving accurately weighted quantities of bisabolol and Poloxamer 407 in ethanol 96% and following vacuum-assisted evaporation at 50 °C and 55 rpm on a rotary evaporator (Buchi, Essen, Germany) until a thin film was formed []. The film was re-hydrated with the required amount of distilled water under sonication at 35 °C for 30 min. The resulting solution was carefully withdrawn using a syringe and a needle and filtered through a 0.22 µm syringe filter.
All samples were stored in hermetically sealed vials at room temperature and protected from light. The composition of each test formulation is presented in Table 1.

Table 1.
Test compositions.
2.2.2. Accelerated Stability Testing
An accelerated physical stability study was conducted via centrifugation at 15,000 rpm for 30 min [,]; all samples were applied in a volume of 0.5 mL. At the end of the test, the visual appearance of the dispersions was observed for phase separation and opalescence. Photographs were taken before and after centrifugation in order to follow any changes arising from the applied forces. A test for resuspendability was performed on the affected samples after that.
2.2.3. DLS
DLS analysis of the samples was carried out on a Zetasizer Ultra Red (λ = 632.8 nm) (Malvern Panalytical Ltd., Malvern, UK) on the day of preparation and after performing the accelerated stability test followed by re-homogenization. The multi-angle DLS (MADLS) technique was applied, based on which data with the highest significance and best repeatability were extracted. All measurements were repeated in triplicate. A t-test was performed for the determination of any statistically significant (p < 0.05) differences between the data obtained before and after stability testing. The calculation was performed by using mean values for each group, standard deviations (SDs), and the number of repetitions (n = 3). Where relevant, the same analysis was performed to compare samples obtained with different solubilization techniques at a constant bisabolol content.
2.2.4. ELS
ELS analysis for zeta potential measurement was performed on a Zetasizer Ultra Red (λ = 632.8 nm) (Malvern Panalytical Ltd., Malvern, UK) on the day of sample preparation at 25 °C by using DTS1070-type cuvettes. The samples were filtered through a 0.22 µm pore size syringe filter before each measurement. All measurements were repeated in triplicate.
2.2.5. Foamability
A foamability test was conducted as 0.5 mL of each sample was vigorously shaken for 30 s and placed to rest on a stand. The height of the foam was measured right after shaking and at chosen times thereafter [].
2.2.6. Viscosimetry
Poloxamer 407 5% micellar solution (bisabolol-free) and the optimal bisabolol-loaded test sample were subjected to viscosimetry on an IKA® Rotavisc lo-vi viscometer (IKA®-Werke GmbH & Co. KG, Staufen, Germany) with the aid of a Spindle №SP-1. The measurements were carried out at a gradient increase at temperatures within 20–40 °C. As a result, temperature–viscosity curves were plotted.
2.2.7. Antimicrobial Activity
The antimicrobial activity of alpha-bisabolol was assessed against Escherichia coli ATCC 25922, Staphylococcus aureus ATCC 25923, and Candida albicans ATCC 10231 reference strains. Two-fold serial dilutions of a bisabolol-loaded sample of 2% (obtained by a film-hydration method) were made in 1.0 mL Mueller–Hinton broth. Each tube was inoculated with 0.1 mL of standardized microbial suspension (McFarland 0.5), after which the samples were aerobically cultivated under the standard conditions for each strain: 24 h at 37 °C for E. coli and S. aureus and 48 h at 35 °C for C. albicans. The minimal inhibitory concentrations (MICs) were determined as the lowest active concentrations by which no visible turbidity is observed. Positive controls (PCs) of all microbial strains were set.
The minimal bactericidal and fungicidal concentrations (MBC/MFC) were determined by a single bacterial-loop-volume transfer of the test suspensions onto blood agar. The so-obtained specimens were incubated once again under the aforementioned conditions. The lowest concentration at which bacterial or fungal growth was 99.9% inhibited was reported as MBC/MFC.
In addition, the cup-plate technique was applied to evaluate the inhibition zones of alpha-bisabolol. For this purpose, dense seeding of all microbial strains was carried out on Muller–Hinton agar. By using a sterile cork-borer, a cylindrical hole with a diameter of 7 mm was drilled in the center of each Petri dish, into which 100 μL of the test sample was placed. The Petri dishes were left for aerobic cultivation under the standard conditions for each strain: 24 h at 37 °C for E. coli and S. aureus and 48 h at 35 °C for C. albicans. Thereafter, the diameter of the manifested zones of inhibition was measured.
All antimicrobial studies were repeated twice.
3. Results and Discussion
3.1. Visual Appearance and Physical Stability
All test samples, except for the pure micellar solution (B-5) and the sample obtained by film hydration with 0.5% bisabolol (FH-5), appeared as low-viscosity dispersions with a slight to notable opalescence (Figure 2). In contrast, B-5 and FH-5 were observed as clear and colorless solutions. In the case of FH-5, this result testifies to a complete solubilization of the oil phase and successful microemulsion formation. The presence of a weak to moderate turbidity in the rest of the formulations is likely a consequence of the presence of a non-solubilized excess of alpha-bisabolol that remains emulsified in the aqueous medium, or a larger size of the bisabolol-loaded micelles.

Figure 2.
Visual appearance of the bisabolol-loaded test samples.
Samples DS-5, FH-5, and FH-10 showed a sustainable appearance over 30 days of storage under standard conditions and after centrifugation for accelerated stability testing. Creaming was observed in samples DS-10, DS-15, and FH-15 after centrifugation and after the second day of storage under standard conditions (Figure 3). All affected samples were easily resuspended after gentle shaking, and the original appearance was completely recovered.

Figure 3.
Centrifugation-induced creaming (pointed out with red arrows) by samples DS-10, DS-15, and FH-15, and stability (no creaming) by sample FH-10.
3.2. Average Size and Size Distribution
MADLS revealed the highest significance and repeatability of the front-angle scan (12.78°) data, wherefore these measurements were taken into account for the comparative purposes of the DLS analysis. Table 2 summarizes the most important parameters derived from the DLS study.

Table 2.
Average hydrodynamic diameter and polydispersity of bisabolol-loaded micellar solutions.
At the lowest bisabolol concentration of 0.5%, both solubilization methods demonstrated effective micellar solubilization and preservation of physical stability, given the minor deviations in PDI and Z-average reported before and after centrifugation. However, the film-hydration method resulted in a smaller average micellar size and lower PDI than direct solubilization. Figure 4 and Figure 5 illustrate the particle size distribution of samples DS-5 and FH-5 before and after performing the accelerated stability test by centrifugation followed by a subsequent resuspension.

Figure 4.
Size distribution by intensity of DS-5 (A) before and (B) after the accelerated stability test.

Figure 5.
Size distribution by intensity of FH-5 (A) before and (B) after the accelerated stability test.
The differences between the solubilization techniques and the respective solubilization capacity of Poloxamer 407 for alpha-bisabolol became more pronounced at the next active concentration level of 1%. According to the DLS data, both FH-10 and DS-10 recovered their dispersity after centrifugation, but FH-10 was distinguished with a smaller average size and significantly lower polydispersity (p < 0.0001). Figure 6 and Figure 7 illustrate the particle size distribution of samples DS-10 and FH-10 before and after performing the accelerated stability test by centrifugation followed by a subsequent resuspension.

Figure 6.
Size distribution by intensity of DS-10 (A) before and (B) after the accelerated stability test.

Figure 7.
Size distribution by intensity of FH-10 (A) before and (B) after the accelerated stability test.
At the highest alpha-bisabolol concentration of 1.5%, both solubilization methods demonstrated an increase in the mean hydrodynamic size and polydispersity, as well as notable differences in the dispersion characteristics before and after centrifugation and resuspension. Figure 8 and Figure 9 illustrate the particle size distribution of samples DS-15 and FH-15 before and after performing the accelerated stability test by centrifugation followed by a subsequent resuspension.

Figure 8.
Size distribution by intensity of DS-15 (A) before and (B) after the accelerated stability test.

Figure 9.
Size distribution by intensity of FH-15 (A) before and (B) after the accelerated stability test.
A relation of the so-obtained results could be made with other published studies. The average hydrodynamic diameter of 0.5% bisabolol-containing microemulsions (29–35 nm) corresponds with the values reported by Tănase et al. and Zhang et al. for curcumin-loaded and naphthalocyanine-loaded Poloxamer 407 micelles, respectively [,]. Other authors established significantly larger average sizes when using lower Poloxamer concentrations (1.0–2.0% w/v), which could be for similar reasons as the discussed here, i.e., the presence of an emulsified excess of the active ingredient [,]. Considering the given values for encapsulation efficiencies (EE%) in other research articles, the typical range of successful active loading into Poloxamer 407 simple or mixed micelles appears to be 0.07–0.5% [,,,,,,]. Specifically, studies using similar Poloxamer concentrations as the one here (5%) are of Basak et al., who reported the inclusion of ibuprofen (log P 3.5), acetylsalicylic acid (log P 1.2), and erythromycin (log P 3.06) at 0.1% in micellar solutions of Poloxamer 407 5.26% []; oxcarbazepine (log P 1.8) was solubilized into Poloxamer 407 5.0% solution by Singla et al. []; resveratrol 0.065% (log P 3.1) was solubilized into Poloxamer 407 6.3% solution by Vivero-lopez et al. []; bisabolol (log P 3.8), in particular, has not been yet widely explored in nano-vesicular systems of this kind. There are several reports of bisabolol-loaded microemulsions obtained with the aid of other surfactants, such as the ones of Nery dos Santos et al. (bisabolol 5% w/w in stabilized with Eumulgin CO40® and Polymol® microemulsion; droplet size of 20.5 ± 0.62 nm is reported) [], Almeida et al. (bisabolol 1% w/w in stabilized with Kolliphor® ELP+Span 80 3:1 nanoemulsion; droplet size of 14.0 ± 0.8 nm and zeta potential of +7.5 ± 1.9 mV are reported) [], and Kim et al. (bisabolol up to 10% w/w solubilized with the aid of polyglyceryl-4 caprate; droplet size > 200 nm and zeta potential of −14.48 ± 0.92 mV are reported) [].
3.3. Zeta Potential
The zeta potential values obtained show a clear tendency for theoretical destabilization with increasing the oil concentration and a greater absolute value for the samples obtained by direct solubilization at all concentration levels (Table 3).

Table 3.
Zeta potential of bisabolol-loaded micellar solutions.
Although the zeta potential values fall in the unfavorable range of −30 to +30 mV, in reality, we observed satisfactory physical stability of all samples obtained with 0.5–1.0% alpha-bisabolol []. It could be claimed that in this particular case, the smaller size and narrow size distribution play a prevailing role in the colloidal stability. Moreover, these results are expected considering the non-ionic nature of the used surfactant; similar findings are reported elsewhere [,,]; any electric potential within Poloxamer 407 micellar solutions could be explained with the repulsive interactions between the polymeric micelles and the loaded active compounds or the presence of ionic contaminants [,,]. Assumably, and vice versa, each reduction in the electric potential within the system might also be explained by the occurrence of attractive forces between the polymer and the loaded active molecules, as is likely the case of this study.
3.4. Foamability
A foamability test was conducted to evaluate the washing potential of the bisabolol-loaded micellar solutions in comparison to free micellar water. The ability to form a foam is well known to be closely related to the presence of surfactants and the cleansing properties of the product []. Under the chosen experimental conditions, all test samples demonstrated the formation of a stable foam persisting for at least 6 h. The presence of solubilized alpha-bisabolol was shown to slightly reduce the initial height of the foam but stabilize it over time. The latter effect became more evident as the concentration of bisabolol increased (Figure 10).

Figure 10.
Foamability and foam stability of free and bisabolol-loaded micellar solutions.
3.5. Viscosity
At the chosen Poloxamer 407 concentration of 5%, both the pure polymeric solution (reference) and the 1% alpha-bisabolol-loaded solubilizate (test) showed low viscosity and liquid consistency with no signs of thermo-gelation up until 40 °C (Figure 11). The viscosity was slightly increased in the presence of solubilized oil, whereas both samples demonstrated a decrease in viscosity with the rise in temperature. Thus, the optimized test formulation could be considered convenient for application on large skin areas if stored under the recommended conditions.

Figure 11.
Temperature–viscosity curves of the reference Poloxamer 5% solution (B-5) and the optimized bisabolol-loaded sample FH-10.
3.6. Antimicrobial Activity
The antimicrobial study revealed the inhibitory activity of the alpha-bisabolol-loaded micellar solution against all microbial strains tested. The minimum inhibitory concentrations (MICs) of alpha-bisabolol against S. aureus, E. coli, and C. albicans were determined (Table 4). At the highest affordable concentration with respect to physical stability, 1%, the compound demonstrated microbicidal activity only against C. albicans; bactericidal activity against S. aureus and E. coli was not established (Figure 12A). However, clear inhibition zones were reported for both C. albicans and E. coli, while the lack of a sterile zone of inhibition by S. aureus confirmed the absence of bactericidal activity against this pathogen (Figure 12B).

Table 4.
Antimicrobial activity of alpha-bisabolol.
Figure 12.
(A) Microbicidal activity of bisabolol; (B) zones of inhibition of bisabolol.
4. Conclusions
This study revealed a better solubilization capacity of Poloxamer 407 5% solution with respect to alpha-bisabolol when the film-hydration method is applied as compared to direct solubilization. The composition obtained by the film-hydration technique with 1% bisabolol (FH-10) was found to be most favorable with respect to fungicidal activity, satisfactory micellar encapsulation, transparency, and physical stability. The optimized formulation was characterized by a suitable viscosity for a cleansing micellar solution and a preserved foaming and washing ability not negatively affected by a solubilized phase of bisabolol. This pilot research presents a successful first step in the development of a cosmetic composition with alpha-bisabolol for facial skin hygiene, providing washing and antimicrobial effects. The obtained results may serve as a background for following research and development, which, in our opinion, should be aiming at further increases in and precise analysis of the encapsulation efficacy of bisabolol within mixed Poloxamer micelles upon the addition of various co-surfactants in the system. The realization of a product suitable for market access may require the inclusion of other excipients to provide the formulation’s long-term chemical and microbiological stability, such as antioxidants and preservatives. Finally, the influence of all other excipients on the investigated parameters herein should also be a subject of further research.
Author Contributions
Conceptualization, N.I.; methodology, N.I. and N.E.; software, N.I.; validation, V.A.; formal analysis, N.I.; investigation, N.I. and N.E.; resources, N.I.; data curation, N.I.; writing—original draft preparation, N.I.; writing—review and editing, V.A.; visualization, N.I.; supervision, V.A.; project administration, V.A.; funding acquisition, V.A. All authors have read and agreed to the published version of the manuscript.
Funding
This study is financed by the European Union—Next Generation EU—through the National Recovery and Resilience Plan of the Republic of Bulgaria, project No. BG-RRP-2.004-0009-C02.
Institutional Review Board Statement
Not applicable.
Informed Consent Statement
Not applicable.
Data Availability Statement
The data presented in this study are available on request from the corresponding author.
Acknowledgments
Special thanks to the Medical University of Varna and the European Union for the financial support provided for the publication of this paper.
Conflicts of Interest
The authors declare no conflicts of interest. The funders had no role in the design of the study; in the collection, analyses, or interpretation of data; in the writing of the manuscript; or in the decision to publish the results.
References
- Eddin, L.B.; Jha, N.K.; Goyal, S.N.; Agrawal, Y.O.; Subramanya, S.B.; Bastaki, S.M.A.; Ojha, S. Health Benefits, Pharmacological Effects, Molecular Mechanisms, and Therapeutic Potential of α-Bisabolol. Nutrients 2022, 14, 1370. [Google Scholar] [CrossRef] [PubMed]
- Souza, F.B.; Souza, R.B.; Moraes, Â.M. Incorporation and release kinetic of alpha-bisabolol from PCL and chitosan/guar gum membranes. Braz. J. Chem. Eng. 2016, 33, 453–467. [Google Scholar] [CrossRef]
- Kamatou, G.P.P.; Viljoen, A.M. A Review of the Application and Pharmacological Properties of α-Bisabolol and α-Bisabolol-Rich Oils. J. Am. Oil. Chem. Soc. 2009, 87, 1–7. [Google Scholar] [CrossRef]
- Available online: https://cosmetics.specialchem.com/inci-ingredients/bisabolol# (accessed on 10 September 2024).
- Lee, J.; Jun, H.; Jung, E.; Ha, J.; Park, D. Whitening effect of α-bisabolol in Asian women subjects. Int. J. Cos. Sci. 2010, 32, 299–303. [Google Scholar] [CrossRef]
- Available online: https://www.ewg.org/skindeep/browse/ingredients/700771-BISABOLOL/?ingredient_id=700771-BISABOLOL&page=3 (accessed on 10 September 2024).
- Christian, S.D.; Scamehorn, J.F. Solubilization in Surfactant Aggregates; CRC Press: Boca Raton, FL, USA, 2020; pp. 31–111. [Google Scholar] [CrossRef]
- Ohshima, H.; Makino, K. Colloid and Interface Science in Pharmaceutical Research and Development; Elsivier: Amsterdam, The Netherlands, 2014; pp. 1–54. [Google Scholar]
- Andrei, F. Dermatopharmacy and Cosmetology Practical Study Guide for Students of the English Section of the Faculty of Pharmacy; Victor Babes: Timisoara, Romania, 2023. [Google Scholar]
- Sakamoto, K.; Lochhead, R.Y.; Maibach, H.I.; Yamashita, Y. Cosmetic Science and Technology; Elsevier: Amsterdam, The Netherlands, 2017. [Google Scholar]
- Sarkic, A.; Stappen, I. Essential Oils and Their Single Compounds in Cosmetics—A Critical Review. Cosmetics 2018, 5, 11. [Google Scholar] [CrossRef]
- Gugleva, V.; Ivanova, N.; Sotirova, Y.; Andonova, V. Dermal Drug Delivery of Phytochemicals with Phenolic Structure via Lipid-Based Nanotechnologies. Pharmaceuticals 2021, 14, 837. [Google Scholar] [CrossRef]
- An, J.Y.; Yang, H.S.; Park, N.R.; Koo, T.-S.; Shin, B.; Lee, E.H.; Cho, S.H. Development of Polymeric Micelles of Oleanolic Acid and Evaluation of Their Clinical Efficacy. Nanoscale Res. Lett. 2020, 15, 1–14. [Google Scholar] [CrossRef]
- Šmejkalová, D.; Muthný, T.; Nešporová, K.; Hermannová, M.; Achbergerová, E.; Huerta-Angeles, G.; Svoboda, M.; Čepa, M.; Machalová, V.; Luptáková, D.; et al. Hyaluronan polymeric micelles for topical drug delivery. Carbohydr. Polym. 2017, 156, 86–96. [Google Scholar] [CrossRef]
- Wichit, A.; Tangsumranjit, A.; Pitaksuteepong, T.; Waranuch, N. Polymeric Micelles of PEG-PE as Carriers of All-Trans Retinoic Acid for Stability Improvement. AAPS Pharm. Sci. Tech. 2012, 13, 336–343. [Google Scholar] [CrossRef][Green Version]
- Lapteva, M.; Möller, M.; Gurny, R.; Kalia, Y.N. Self-assembled polymeric nanocarriers for the targeted delivery of retinoic acid to the hair follicle. Nanoscale 2015, 7, 18651–18662. [Google Scholar] [CrossRef]
- Kandekar, S.G.; del Río-Sancho, S.; Lapteva, M.; Kalia, Y.N. Selective delivery of adapalene to the human hair follicle under finite dose conditions using polymeric micelle nanocarriers. Nanoscale 2018, 10, 1099–1110. [Google Scholar] [CrossRef] [PubMed]
- Kahraman, E.; Ÿzhan, G.; Ÿzsoy, Y.; Güngör, S. Polymeric micellar nanocarriers of benzoyl peroxide as potential follicular targeting approach for acne treatment. Colloids Surf. B Biointerfaces 2016, 146, 692–699. [Google Scholar] [CrossRef]
- Lapteva, M.; Mondon, K.; Möller, M.; Gurny, R.; Kalia, Y.N. Polymeric Micelle Nanocarriers for the Cutaneous Delivery of Tacrolimus: A Targeted Approach for the Treatment of Psoriasis. Mol. Pharm. 2014, 11, 2989–3001. [Google Scholar] [CrossRef] [PubMed]
- Khurana, B.; Arora, D.; Narang, R.K. QbD based exploration of resveratrol loaded polymeric micelles based carbomer gel for topical treatment of plaque psoriasis: In vitro, ex vivo and in vivo studies. J. Drug Deliv. Sci. Technol. 2020, 59, 101901. [Google Scholar] [CrossRef]
- Bachhav, Y.; Mondon, K.; Kalia, Y.; Gurny, R.; Möller, M. Novel micelle formulations to increase cutaneous bioavailability of azole antifungals. J. Control. Release 2011, 153, 126–132. [Google Scholar] [CrossRef] [PubMed]
- Abd-Elsalam, W.H.; El-Zahaby, S.A.; Al-Mahallawi, A.M. Formulation and in vivo assessment of terconazole-loaded polymeric mixed micelles enriched with Cremophor EL as dual functioning mediator for augmenting physical stability and skin delivery. Drug Deliv. 2018, 25, 484–492. [Google Scholar] [CrossRef] [PubMed]
- Parra, A.; Jarak, I.; Santos, A.; Veiga, F.; Figueiras, A. Polymeric Micelles: A Promising Pathway for Dermal Drug Delivery. Materials 2021, 14, 7278. [Google Scholar] [CrossRef]
- Zakharova, L.Y.; Vasilieva, E.A.; Mirgorodskaya, A.B.; Zakharov, S.V.; Pavlov, R.V.; Kashapova, N.E.; Gaynanova, G.A. Hydrotropes: Solubilization of nonpolar compounds and modification of surfactant solutions. J. Mol. Liq. 2023, 370, 120923. [Google Scholar] [CrossRef]
- Chen, P. Molecular Interfacial Phenomena of Polymers and Biopolymers; Woodhead Publishing: Sawston, UK, 2005. [Google Scholar]
- Kumar, P.; Mittal, K.L. Handbook of Microemulsion Science and Technology; CRC Press: Boca Raton, FL, USA, 2018. [Google Scholar]
- Karunaratne, D.N.; Pamunuwa, G.; Ranatunga, R.J.K.U. Properties and Uses of Microemulsions; InTech: London, UK, 2017. [Google Scholar]
- Mahdi, E.S.; Sattar, M.; Sakeena, M.H.F.; Abdulkarim, M.; Noor, A.M.; Abdullah, G. Effect of surfactant and surfactant blends on pseudoternary phase diagram behavior of newly synthesized palm kernel oil esters. Drug Des. Devel. Ther. 2011, 5, 311. [Google Scholar] [CrossRef]
- Khan, K.U.; Minhas, M.U.; Badshah, S.F.; Suhail, M.; Ahmad, A.; Ijaz, S. Overview of nanoparticulate strategies for solubility enhancement of poorly soluble drugs. Life Sci. 2022, 291, 120301. [Google Scholar] [CrossRef]
- Salager, J.-L.; Antón, R.; Bullón, J.; Forgiarini, A.; Marquez, R. How to Use the Normalized Hydrophilic-Lipophilic Deviation (HLDN) Concept for the Formulation of Equilibrated and Emulsified Surfactant-Oil-Water Systems for Cosmetics and Pharmaceutical Products. Cosmetics 2020, 7, 57. [Google Scholar] [CrossRef]
- Witthayapanyanon, A.; Harwell, J.H.; Sabatini, D.A. Hydrophilic–lipophilic deviation (HLD) method for characterizing conventional and extended surfactants. J. Colloid Interface Sci. 2008, 325, 259–266. [Google Scholar] [CrossRef] [PubMed]
- Ghayour, A. A methodology for measuring the characteristic curvature of technical-grade ethoxylated nonionic surfactants: The effects of concentration and dilution. Tenside Surfact. Det. 2023, 60, 1–12. [Google Scholar] [CrossRef]
- Zarrintaj, P.; Ramsey, J.D.; Samadi, A.; Atoufi, Z.; Yazdi, M.K.; Ganjali, M.R.; Amirabad, L.M.; Zangene, E.; Farokhi, M.; Formela, K.; et al. Poloxamer: A versatile tri-block copolymer for biomedical applications. Acta Biomater. 2020, 110, 37–67. [Google Scholar] [CrossRef]
- Dumortier, G.; Grossiord, J.L.; Agnely, F.; Chaumeil, J.C. A Review of Poloxamer 407 Pharmaceutical and Pharmacological Characteristics. Pharm. Res. 2006, 23, 2709–2728. [Google Scholar] [CrossRef]
- European Directorate for the Quality of Medicines & HealthCare of the Council of Europe (EDQM). European Pharmacopoeia; Council of Europe 10.0: Strasbourg, France, 2019; pp. 3052–3054. [Google Scholar]
- Bodratti, A.; Alexandridis, P. Formulation of Poloxamers for Drug Delivery. J. Funct. Biomater. 2018, 9, 11. [Google Scholar] [CrossRef]
- Ivanova, N.; Ermenlieva, N.; Simeonova, L.; Vilhelmova-Ilieva, N.; Bratoeva, K.; Stoyanov, G.; Andonova, V. In Situ Gelling Behavior and Biopharmaceutical Characterization of Nano-Silver-Loaded Poloxamer Matrices Designed for Nasal Drug Delivery. Gels 2024, 10, 385. [Google Scholar] [CrossRef]
- Russo, E.; Villa, C. Poloxamer Hydrogels for Biomedical Applications. Pharmaceutics 2019, 11, 671. [Google Scholar] [CrossRef]
- Cui, N.; Dai, C.-Y.; Mao, X.; Lv, X.; Gu, Y.; Lee, E.-S.; Jiang, H.-B.; Sun, Y. Poloxamer-Based Scaffolds for Tissue Engineering Applications: A Review. Gels 2022, 8, 360. [Google Scholar] [CrossRef]
- Sedlarikova, J.; Janalikova, M.; Egner, P.; Pleva, P. Poloxamer-Based Mixed Micelles Loaded with Thymol or Eugenol for Topical Applications. ACS Omega 2024, 9, 23209–23219. [Google Scholar] [CrossRef]
- Estanqueiro, M.; Conceição, J.; Amaral, M.H.; Santos, D.; Silva, J.B.; Lobo, J.M.S. Characterization and stability studies of emulsion systems containing pumice. Braz. J. Pharm. Sci. 2014, 50, 361–369. [Google Scholar] [CrossRef]
- Navarro-Pérez, Y.M.; Cedeño-Linares, E.; Norman-Montenegro, O.; Ruz-Sanjuan, V.; Mondeja-Rivera, Y.; Hernández-Monzón, A.M.; González-Bedia, M.M. Prediction of the physical stability and quality of O/W cosmetic emulsions using full factorial design. J. Pharm. Pharmacogn. Res. 2021, 9, 98–112. [Google Scholar] [CrossRef] [PubMed]
- Petkova, B.; Tcholakova, S.; Denkov, N. Foamability of surfactant solutions: Interplay between adsorption and hydrodynamic conditions. Colloids Surf. A Physicochem. Eng. Asp. 2021, 626, 127009. [Google Scholar] [CrossRef]
- Tănase, M.A.; Soare, A.C.; Diţu, L.M.; Nistor, C.L.; Mihaescu, C.I.; Gifu, I.C.; Petcu, C.; Cinteza, L.O. Influence of the Hydrophobicity of Pluronic Micelles Encapsulating Curcumin on the Membrane Permeability and Enhancement of Photoinduced Antibacterial Activity. Pharmaceutics 2022, 14, 2137. [Google Scholar] [CrossRef] [PubMed]
- Zhang, Y.; Jeon, M.; Rich, L.J.; Hong, H.; Geng, J.; Zhang, Y.; Shi, S.; Barnhart, T.E.; Alexandridis, P.; Huizinga, J.D.; et al. Non-invasive multimodal functional imaging of the intestine with frozen micellar naphthalocyanines. Nat. Nanotechnol. 2014, 9, 631–638. [Google Scholar] [CrossRef]
- Mauludin, R.; Müller, R.H. Preparation and storage stability of rutin nanosuspensions. J. Pharm. Investig. 2013, 43, 395–404. [Google Scholar] [CrossRef]
- Basak, R.; Bandyopadhyay, R. Encapsulation of Hydrophobic Drugs in Pluronic F127 Micelles: Effects of Drug Hydrophobicity, Solution Temperature, and pH. Langmuir 2013, 29, 4350–4356. [Google Scholar] [CrossRef]
- Singla, P.; Chabba, S.; Mahajan, R.K. A systematic physicochemical investigation on solubilization and in vitro release of poorly water soluble oxcarbazepine drug in pluronic micelles. Colloids Surf. A Physicochem. Eng. Asp. 2016, 504, 479–488. [Google Scholar] [CrossRef]
- Saxena, V.; Hussain, M.D. Poloxamer 407/TPGS mixed micelles for delivery of gambogic acid to breast and multidrug-resistant cancer. Int. J. Nanomed. 2012, 7, 713–721. [Google Scholar] [CrossRef]
- Nagy, N.Z.; Varga, Z.; Mihály, J.; Domján, A.; Fenyvesi, É.; Kiss, É. Highly Enhanced Curcumin Delivery Applying Association Type Nanostructures of Block Copolymers, Cyclodextrins and Polycyclodextrins. Polymers 2020, 12, 2167. [Google Scholar] [CrossRef]
- Vivero-Lopez, M.; Sparacino, C.; Quelle-Regaldie, A.; Sánchez, L.; Candal, E.; Barreiro-Iglesias, A.; Huete-Toral, F.; Carracedo, G.; Otero, A.; Concheiro, A.; et al. Pluronic®/casein micelles for ophthalmic delivery of resveratrol: In vitro, ex vivo, and in vivo tests. Int. J. Pharm. 2022, 628, 122281. [Google Scholar] [CrossRef] [PubMed]
- Nery Dos Santos, Q.; Teles, D.C.S.; de Araujo, G.R.S.; Lima, O.V.A.; Silva, L.A.S.; de Carvalho, R.C.V.; Carlos de Sousa, V.; Matos, S.S.; Costa, A.M.B.; Andrade-Neto, V.V.; et al. Microemulsions strongly promoted the activity of α-bisabolol against different Leishmania species and its skin permeation. Exp. Parasitol. 2024, 265, 108808. [Google Scholar] [CrossRef]
- Almeida, E.A.T.; Ferreira-Nunes, R.; Aguiar, B.R.L.; dos Reis, P.E.D.; Gratieri, T.; Cunha-Filho, M.; Gelfuso, G.M. Aqueous-based Nanoemulsion Containing (-)-α-bisabolol for Topical Treatment of Skin Burns. Curr. Cosmet. Sci. 2022, 1, e090721194664. [Google Scholar] [CrossRef]
- Kim, S.; Yu, S.; Kim, J.; Khaliq, N.U.; Choi, W.I.; Kim, H.; Sung, D. Facile Fabrication of α-Bisabolol Nanoparticles with Improved Antioxidant and Antibacterial Effects. Antioxidants 2023, 12, 207. [Google Scholar] [CrossRef]
- Malvern® Panalytical. Zetasizer Advance Series User Guide. 2022. Available online: https://www.malvernpanalytical.com/en/learn/knowledge-center/user-manuals/man0592en (accessed on 10 August 2024).
- Yorke, K.; Amin, S. High Performance Conditioning Shampoo with Hyaluronic Acid and Sustainable Surfactants. Cosmetics 2021, 8, 71. [Google Scholar] [CrossRef]
Disclaimer/Publisher’s Note: The statements, opinions and data contained in all publications are solely those of the individual author(s) and contributor(s) and not of MDPI and/or the editor(s). MDPI and/or the editor(s) disclaim responsibility for any injury to people or property resulting from any ideas, methods, instructions or products referred to in the content. |
© 2024 by the authors. Licensee MDPI, Basel, Switzerland. This article is an open access article distributed under the terms and conditions of the Creative Commons Attribution (CC BY) license (https://creativecommons.org/licenses/by/4.0/).